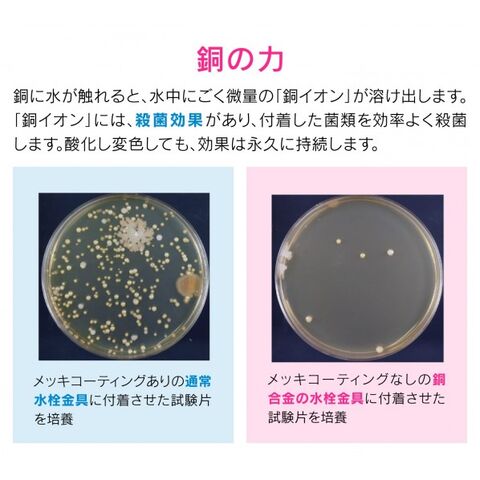

3/2
時点_ポイント最大11倍
GAONA ガオナ ガーデン用万能ホーム水栓 おしゃれ 取付ネジ:呼13(PJ1/2) レトロ GA-RA003 1個
販売価格
10,056
円 (税込)
送料無料
- 出荷目安:
- 約4営業日(土日祝除く)
たまるdポイント(通常) 91
+キャンペーンポイント(期間・用途限定) 最大10倍
※たまるdポイントはポイント支払を除く商品代金(税抜)の1%です。
※表示倍率は各キャンペーンの適用条件を全て満たした場合の最大倍率です。
各キャンペーンの適用状況によっては、ポイントの進呈数・付与倍率が最大倍率より少なくなる場合がございます。
dカードでお支払ならポイント3倍
各キャンペーンの適用状況によっては、ポイントの進呈数・付与倍率が最大倍率より少なくなる場合がございます。
- 商品情報
- レビュー
特徴
材質:青銅
◆散水ジョイントパイプが付いたオシャレなガーデン用水栓です。
◆ホーセンド付きのホースとワンタッチで接続できます。
◆固定コマ仕様になります。
※使用を重ねるうちに、落ち着いた色調に表面が変化していきます。
仕様
| サイズ | 取付ネジ:呼13(PJ1/2) | 重量 | 540 |
| 入数 | 1個 |